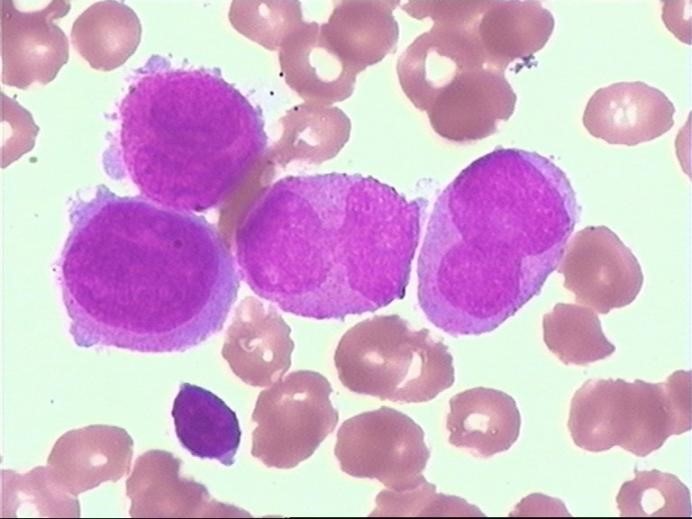

细胞工厂的“罢工危机”
清晨的骨髓涂片在显微镜下铺开一片血色的原野,这里是人体最繁忙的细胞工厂。正常情况下,数以万计的造血干细胞如同训练有素的工人,沿着成熟的生产线有序工作:从稚嫩的"学徒"早幼粒细胞,逐步成长为携带抗菌武器的"战士"中性粒细胞。但在这张来自32岁教师的骨髓片里,流水线发生了可怕的罢工。
数以千计的早幼粒细胞堆积在视野中,像卡在传送带上的半成品。这些本该继续发育的细胞,突然集体停止了成长。它们的体积比正常细胞大上一圈,仿佛膨胀的气球,细胞核不是规整的圆形,而是扭成怪异的花生状或马蹄形。最触目惊心的是胞浆里撒满的紫色颗粒——本该用于杀灭细菌的武器弹药,此刻却像胡乱堆放的炸药包,随时可能引爆整个造血系统。
巨型早幼粒细胞(18-20微米)占据视野
在这些失控的细胞深处,显微镜捕捉到闪着寒光的"Auer小体"。这些针状结晶如同散落的玻璃碴,是恶性早幼粒细胞的"身份徽章"。当瑞氏染色将细胞核染成妖异的紫红色,整个画面宛如被按下暂停键的灾难现场:90%的骨髓空间被这些发育停滞的叛逆者占据,正常血细胞已被挤压得无处容身。


Auer小体("恶性细胞身份证") 颗粒分布异常堆积
这种被称为急性早幼粒细胞白血病(APL)的疾病,本质上是细胞工厂的调度系统崩溃。正常情况下,遗传基因如同精密的程序代码,指挥细胞按步骤成熟。但当15号与17号染色体发生错位,相当于工厂主控电脑被植入病毒,导致早幼粒细胞们集体"躺平"拒绝分化。它们像卡在青春期的少年,既不能成长为有用的战士,又不肯安静消亡,最终堵塞了整个造血生产线。
令人惊叹的是,现代医学找到了重启系统的"安全密钥"。全反式维甲酸就像精准的基因修复程序,能重新激活这些罢工细胞的成熟机制。配合三氧化二砷治疗,相当于给失控的细胞安装"自毁装置"。治疗成功的骨髓片中,那些张牙舞爪的早幼粒细胞会逐渐收敛锋芒,重新踏上发育的正轨——这不仅是医学的胜利,更是对生命自我修复能力的礼赞。
当我们凝视这些畸变的细胞时,实际上是在解码生命最细微的求救信号。每一个异常的颗粒、每一根Auer小体,都是人体写在细胞层面的病理日记。而破解这些密码的过程,正是现代医学在微观世界书写的侦探传奇。